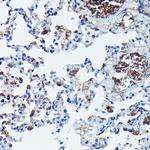
APOBEC3G Antibody in Immunohistochemistry (Paraffin) (IHC (P))

Search
Invitrogen
APOBEC3G Polyclonal Antibody
{{$productOrderCtrl.translations['antibody.pdp.commerceCard.promotion.promotions']}}
{{$productOrderCtrl.translations['antibody.pdp.commerceCard.promotion.viewpromo']}}
{{$productOrderCtrl.translations['antibody.pdp.commerceCard.promotion.promocode']}}: {{promo.promoCode}} {{promo.promoTitle}} {{promo.promoDescription}}. {{$productOrderCtrl.translations['antibody.pdp.commerceCard.promotion.learnmore']}}

Please note: We are reviewing Western blot images included in the antibody testing data in our catalog, including those provided by third parties. Unless expressly labeled or annotated as “raw-unedited”, Western blot images included in the antibody testing data in our catalog may have been edited, optimized or otherwise adjusted for presentation.
产品信息
PA5-89318
种属反应
宿主/亚型
分类
类型
抗原
偶联物
形式
浓度
规格
纯化类型
保存液
内含物
保存条件
运输条件
RRID
产品详细信息
Positive Samples: Cellular Location: Cytoplasm, Nucleus, P-body
靶标信息
The Apoliprotein B mRNA-editing, enzyme-catalytic, polypeptide-like (APOBEC) 3 is a multi-isoform member of the cytidine deaminase family of enzymes that act on monomeric nucleoside and nucleotide substrates. Similar to TRIM5-a which targets incoming retroviral capsids, APOBEC3 plays a major role in cellular defense against retroviral infection as at least two isoforms, APOBEC3G and to a lesser extent APOBEC3F, can be incorporated HIV-1 virions and induce hypermutation in the newly synthesized viral DNA and thus destabilize the viral genome. This innate mechanism of retroviral resistance is counteracted by the HIV-1 Vif protein by inducing the ubiquitization and degradation of APOBEC3G; a single amino acid substitution (D128K) blocks APOBEC3G depletion without affecting its inhibitory activity.
仅用于科研。不用于诊断过程。未经明确授权不得转售。
篇参考文献 (0)
生物信息学
蛋白别名: apolipoprotein B editing complex 3; Apolipoprotein B mRNA-editing complex 3; Arp3; ASGP-R2; ASGPR2; CEM-15; CEM15; CLEC4H2; DNA dC->dU-editing enzyme APOBEC-3; FLJ12740; HBXBP; HL-2; OTTHUMP00000028911; recovery from Friend virus 3
基因别名: Apobec3; Arp3; BC003314; Cem15; Rfv3
UniProt ID: (Mouse) Q99J72
Entrez Gene ID: (Mouse) 80287



